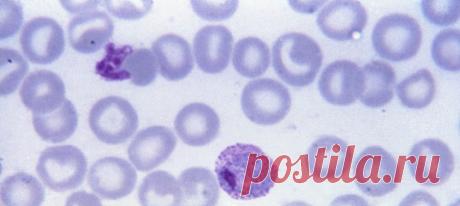
Благодаря участию добровольцев, стало известно много нового о возбудителях малярии и ранних этапах течения болезни – а ведь она постоянно угрожает по меньшей мере четырём миллиардам человек на планете!
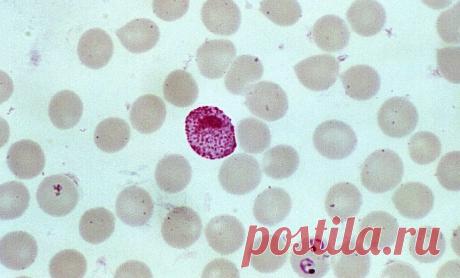
Ученые выявили в геноме возбудителя малярии сотни потенциальных "мишеней" для лекарств | Наука и технологии

Малярия
gazeta.ru
Врачи объяснили, как не подхватить лихорадку Западного Нила от укуса комара. Укусы комаров могут привести не только к зуду, но и к заражению опасными заболеваниями. Чаще всего они переносят малярию, но есть также вероятность подхватить другие недуги, к примеру, лихорадку Западного Нила, рассказал врач-иммунолог ...
lenta.ru
С глобальной проблемой решили бороться танцами. Участники карнавала в Рио-де-Жанейро выступили против нелегальных золотых старателей. Свое выступление перед 70 тысячами зрителей танцоры посвятили индейцам Амазонии, пишет Associated Press. В Бразилии насчитывается 30 тысяч индейцев яномами. Незаконная добыча золота приводит к вспышкам малярии и голоду в общинах.
gazeta.ru
Ученые связали смерть 17 тыс. больных COVID-19 с препаратом от малярии. Французские исследователи высчитали, что около 16,9 тысячи человек могли скончаться из-за приема гидроксихлорохина во время первой волны пандемии коронавируса. Об этом написали в журнале Biomedicine & amp; Pharmacotherapy. Исследование ...
lenta.ru
Человечеству предрекли провал в борьбе с тремя опаснейшими болезнями. Глобальное изменение климата и вооруженные конфликты в мире мешают людям побороть СПИД, туберкулез и малярию. Провал в избавлении от трех опаснейших болезней человечеству предрекли специалисты The Global Fund to Fight AIDS, Tuberculosis and Malaria в своем ежегодном отчете.
lenta.ru
Найден первый антибиотик с мышьяком для борьбы с устойчивостью бактерий. Ученые Флоридского международного университета нашли первый природный антибиотик, содержащий мышьяк, для борьбы с устойчивостью бактерий и малярией. Оказалось, что AST предотвращает заражение комаров Plasmodium falciparum паразитом, вызывающим малярию, в отличие от других современных противомалярийных препаратов.
lenta.ru
Терапевт предупредил о болезнях из-за укусов комаров. Отдыхающие в теплых странах могут привезти в Россию комаров — переносчиков опасных болезней, предупредил врач-терапевт Андрей Кондрахин. По его словам, насекомые, обитающие в Крыму, Грузии, Абхазии и Южной Африке, могут быть переносчиками большого количества инфекций, самое частое из которых — малярия.
lenta.ru
Паразитолог оценил вероятность заражения малярией в России. Директор Института медицинской паразитологии, тропических и трансмиссивных заболеваний имени Марциновского Первого Московского государственного медицинского университета имени Сеченова Минздрава России Александр Лукашев оценил вероятность заражения малярией в России, отметив, что она равна нулю.
lenta.ru
В Таиланде предупредили туристов о подстерегающей в стране опасности. В Таиланде в 2023 году ожидается рост числа случаев заболевания малярией в 3 раза, лихорадкой Денге — в 4,5 раза. Генеральный директор департамента Тарес Крассанайравивонг подчеркнул, что в 2022 году в Таиланде было зарегистрировано 10,1 тысячи случаев малярии и 45,1 тысячи случаев лихорадки Денге.
lenta.ru
Разработан новый эффективный препарат против малярии. Специалисты из Национального института аллергии и инфекционных заболеваний США (NIAID) разработали новый эффективный способ предотвращения малярии. Для этого они создали вакцину на основе моноклональных антител. Результаты показали, что при высокой дозировке эффективность препарата достигала 88,2 процента.
ok.ru
ЦЕЛЕБНАЯ ЧЕРЕМША
Ценится черемша за свои уникальные свойства, приносящие огромную пользу организму человека.
Еще в Древнем Риме черемшу считали хорошим средством, очищающим желудок и кровь. Как "кровоочищающее средство" черемша и поныне употребляется в народной медицине многих стран, - ее назначают при кожных сыпях и золотушных лишаях, гнойничковых заболеваниях кожи.
Водный настой листьев пьют при простуде, малярии, истощении, болезнях желудка и кишечника, отсутстви...
lenta.ru
ВОЗ одобрила применение первой в мире вакцины от малярии. Всемирная организация здравоохранения одобрила применение первой в мире вакцины от малярии RTS,S и рекомендовала начать ее использование по всему миру. По мнению специалистов, применение этой вакцины в качестве дополнения к уже существующим средствам профилактики малярии поможет ежегодно спасать тысячи детей в Африке.
lenta.ru
В Африке зафиксировали неуязвимую к лекарствам малярию. Ученые зафиксировали в Уганде устойчивую форму малярии, которая способна сопротивляться самому широко используемому лекарству. К 2019 году почти 20 процентов образцов малярийного плазмодия, полученных при взятии крови у пациентов, имели генетические мутации, делающие лечение неэффективным.
lenta.ru
В российском городе выявили малярию. В Пскове медики выявили малярийную инфекцию у пациента, поступившего в реанимацию. По словам медиков, ранее в другом медучреждении пациенту поставили диагноз острый тонзиллит и острая почечно-печеночная недостаточность. Пациента перевели в федеральную клинику, россиянин пришел в сознание.
lenta.ru
России предрекли волну эпидемий из-за потепления. Врач-терапевт, клинический фармаколог Андрей Кондрахин рассказал, что изменения климата приводят к тому, что в России все чаще фиксируют появление болезней, характерных для более теплых регионов. Вскоре серьезной проблемой для страны могут стать такие заболевания, как малярия, желтая лихорадка и другие.
myuspehlife.ru
15 самых непосещаемых стран мира. Часть вторая. | Журнал "JK" Джей Кей Почему сюда не едут: За Соломоновыми островами закрепилась репутация чего-то крайне небезопасного – в первую очередь, из-за затяжных международных конфликтов. Малярия, неразвитая инфраструктура и скудное количество воздушных рейсов популярности стране вовсе не прибавляют.
Подгруженный файл
20 августа отмечается Всемирный день комара. Эта дата призвана напомнить об угрозе малярии и других болезней, которые переносятся одним из самых смертельно опасных существ в мире. В честь этого – наша подборка интересных фактов о комарах и борьбе с ними. 1) Наука против вампиров: bit.ly/sciencevsvampires 2) Как комар пьет кровь: видео. bit.ly/bloodsucking 3) Неправильные комары охотятся на своих сородичей: bit.ly/wrongvampires. 4) Почему капли дождя не убивают комаров: bit.ly/surviveraindrops…
vk.com
💬 Вирусы и микробы: научный блокбастер Место действия — виртуальная реальность. В главных ролях — бубонная чума и желтая лихорадка (вот эта симпатяга на картинке). Они, конечно, пытаются навредить. Им противостоят исследователь Елена, иммунитет и искусственный интеллект. Они предлагают вирусам и бактериям не тратить силы в бесполезной борьбе, а присоединиться к делу мира: стать агентами под прикрытием. Вирус желтой лихорадки может убивать простейших, вызывающих малярию, а бактерии чумы —…
ok.ru
ПОЛЫНЬ СПАСАЕТ ОТ РАКА
Не так давно было установлено, что Артемизинин, "Artemisia Annua" или как говорят в народе - просто "полынь", способствует уничтожению клеток рака легких на 98%. Причем этого результата можно достичь всего за 16 часов!Эксперименты ученых доказывают, что травянистое растение полынь не оказывает негативное воздействие на клетки легких, которые находятся в здоровом состоянии.
В прошлом полынь использовали для лечения малярии. Но сегодня доказано учеными...
vk.com
25 Апреля 2019 г. – Четверг • Великий четверг • День дочери • Всемирный день пингвинов (World Penguin Day) • День бумажных самолетиков • Международный день ДНК66 лет • День встречи на Эльбе74 года • День Общества красных шляпок • День чеченского языка • Всемирный день борьбы против малярии (World Malaria Day)11 лет • День памяти апостола и евангелиста Марка День девушек (Первый день лета) - Исландия • День казахстанского футбола • День посадки деревьев - Германия • День освобождения от фашизма…
ok.ru
НАРОДНЫЕ ИЗРЕЧЕНИЯ О ТРАВАХ:
- Как из муки не испечешь хлеба, так без зверобоя не вылечишь человека
-Лук да баня все правят
-Если весть грибок в ногах-по траве носись в лугах
-Натощак зуб чеснока-сутки вирус в дураках
-Приложи к радикулиту лист от хрена свежий, битый
-Коль желудок портит стул-подорожник ешь как мул
-Малярии нет в помине, коль спишь в ворохе полыни
-Болят суставы и спина-вотри репейник-семена
-Глицерин, лимон и мед съешь, и кашель отойдет
-Мед, лимоны и че...
narodnayamedicyna.ru
Полезные свойства чабреца для организма человека Чабрец — это полезная трава, которая растет в лесах, со средней влажностью, встречается в горной местности. Цветы чабреца имеют розоватый оттенок и приятный аромат. В давние времена - это лекарственное средство использовали от проказы и малярии...